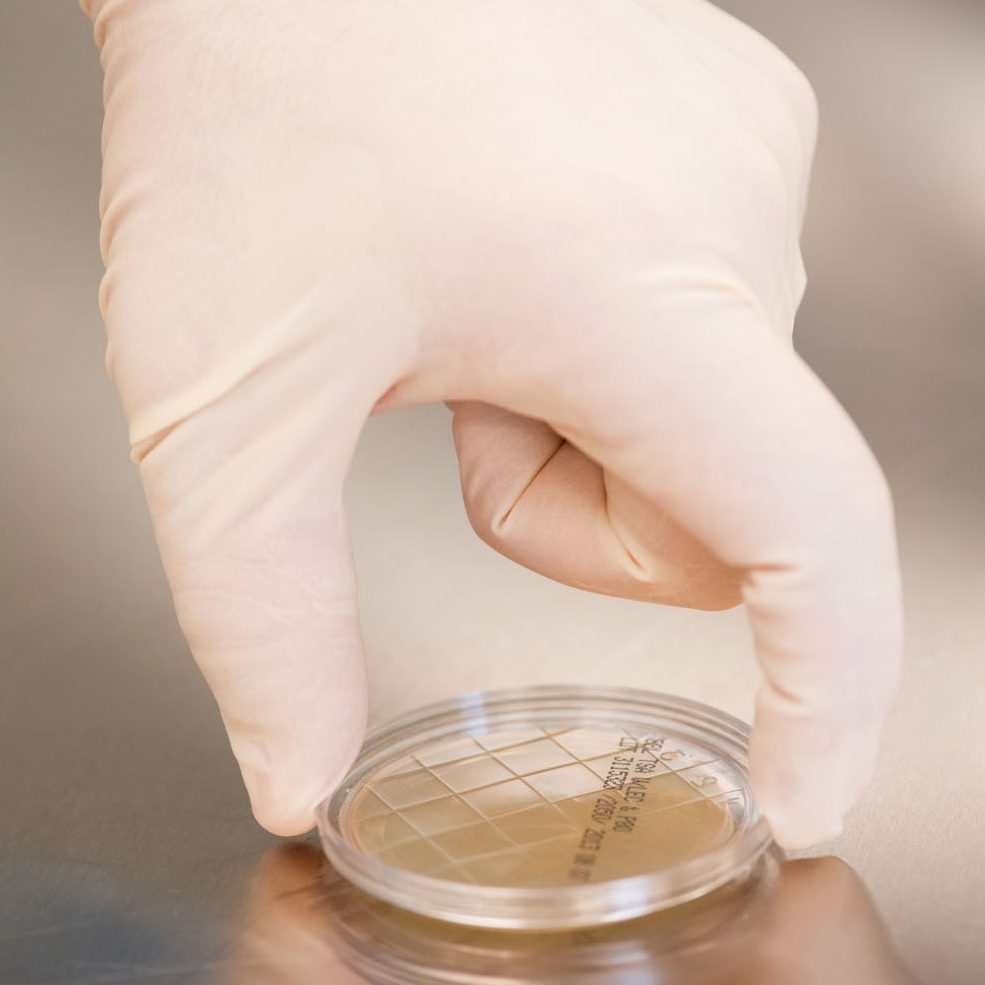
Surface Sampling Image

About On-site Clean
Founded in 2016, On-Site Clean was established on the principles of partnership, reliability, and trust within the evolving pharmacy compounding industry. The company was created to address a critical need: ensuring the proper cleaning and maintenance of ISO-classified cleanrooms and supporting safe, compliant operations within sterile compounding suites.
At On-Site Clean, our mission is to protect patients by helping pharmacies achieve the highest standards of compliance, safety, and quality in sterile and non-sterile compounding environments.
On-Site Clean host of services includes:
-
- Pharmacy Cleanroom cleaning and disinfecting services in line with USP 797 and USP 800 guidelines.
- Primary engineering control (hood) certification, including biological safety cabinets
- Environmental surface sampling (routine and monthly programs)
- Personnel competency testing
- Hand hygiene and garbing assessments, including gloved fingertip sampling
- Aseptic manipulation competency through media fill testing
Headquartered in St. Louis, Missouri, On-Site Clean is a rapidly growing organization supporting health systems and compounding pharmacies across the Midwest and Southeast United States.
Why us?
Every pharmacy is unique in its layout, staffing model, operational demands, and budget. On-Site Clean is committed to serving as a flexible partner, providing solutions tailored to support your facility’s specific needs and long-term growth.
Whether your pharmacy requires comprehensive cleaning services, à la carte support, or assistance on an as-needed basis, On-Site Clean is equipped to help strengthen and maintain your compliance program. Our goal is to work alongside pharmacy leadership to ensure compounding environments remain safe, controlled, and aligned with current regulatory standards.
Founded on the principle that every process ultimately serves the patient, On-Site Clean remains dedicated to supporting pharmacies in maintaining the highest standards of safety, quality, and regulatory compliance.
On-Site Clean Client Retention
As a strategic growth organization operating in close alignment with our distribution partners, we continually evaluate and enhance our services to ensure they meet—and exceed—the expectations of our clients. Client feedback plays a critical role in our quality improvement process and helps guide our ongoing service development. Direct client input remains our most valuable measure of performance and effectiveness. Our success is rooted in long-term partnerships, demonstrated by a client retention rate of 99.1% and strong referral relationships. We deeply value the trust placed in us and remain committed to supporting our partner-clients with the highest standards of service and accountability.
How Can We Help?
Client Contact Form
On-Site Clean Clients